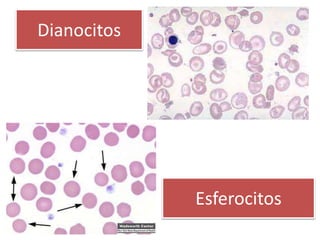
Dianocitos
Esferocitos
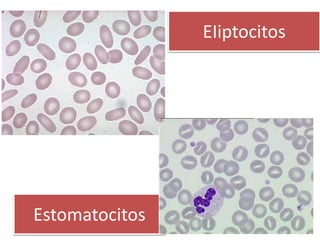
EIiptocitos
Estomatocitos
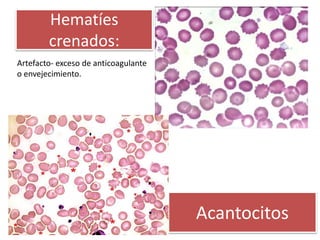
Hematíes
crenados:
Artefacto- exceso de anticoagulante
o envejecimiento.
Acantocitos
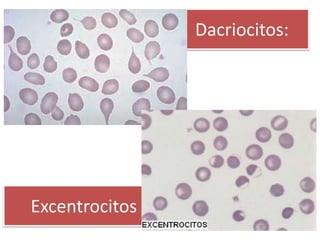
Dacriocitos:
Excentrocitos

Este documento resume las principales enfermedades hematológicas que afectan la producción de sangre y sus componentes. Explica los procesos de hematopoyesis y eritropoyesis, y describe las características normales y alteraciones de eritrocitos, leucocitos y plaquetas. Las alteraciones incluyen anemias, policitemias, neutrofilias, linfocitosis, eosinofilia, trombocitopenia y macroplaquetas, asociadas a diferentes enfermedades y estados fisiopatológicos.